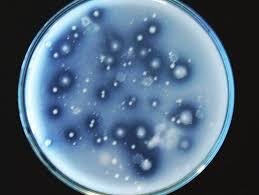
LOS BENEFICIOS DE USAR BACTERIAS SOLUBILIZADORAS DE FOSFATO Y CUALES SON LOS PRODUCTOS DISPONIBLES EN EL MERCADO

Análisis Agropecuarios
Somos un laboratorio de análisis agropecuarios con más de 26 años de trayectoria en análisis de agua, semilla y suelos para el agro. Nuestra misión es brindar asesoramiento a productores y técnicos en el diagnóstico de resultados, sumando eficiencia y compromiso con el medio ambiente.
Contamos con Profesionales altamente calificados, equipos calibrados y de última tecnología para obtener resultados confiables, brindamos atención personalizada y asesoramiento técnico que nos diferencian. Además participamos de programas de control de calidad internos y externos, para ofrecer un servicio de excelencia.
Somos un equipo compromentido a contribuir con la eficiencia y sustentabilidad del campo Argentino
ANÁLISIS FCO-QUÍMICOS
ANÁLISIS MICROBIOLÓGICOS
tus suelos?
MAXIMIZÁ TU PRODUCCIÓN
CONTACTO
- Gral. Roca 1, Villa Nueva, Córdoba, Argentina
- Fuera del horario comercial, recepción de muestras por buzón
 +54-9353 5 65 35 25
+54-9353 5 65 35 25- analisisagropecuariosvm@gmail.com
- LUNES A VIERNES 8 A 13 Y 14 A 19H SÁBADO 8 A 12
ACREDITACIONES Y NORMAS
BLOG
El fósforo (P) es un macronutriente esencial para el crecimiento y desarrollo de las plantas. Los suelos agrícolas contienen grandes cantidades de P, pero en formas no asimilables por las plantas. Sin embargo, muchos microorganismos de suelo tienen la capacidad de transformar el P a formas solubles, entre ellos se destacan las bacterias solubilizadoras de fosfatos (BSF) que constituyen una excelente alternativa para reducir la cantidad de fertilizantes aplicados a diferentes cultivos.
Read MoreLa soja es uno de los cultivos más importantes a nivel mundial. Sin embargo, está expuesta a una variedad de enfermedades fúngicas que pueden afectar su salud y reducir los rendimientos. Es fundamental contar con una estrategia, como el uso de los fungicidas que controlan el crecimiento y la propagación de los hongos que causan estas enfermedades. Actualmente, una alternativa más sostenible y segura que los fungicidas químicos, son los fungicidas biológicos foliares.
Read MoreInoculantes con Bacillus spp. presentan un enorme potencial para promover una agricultura sustentable, incrementando la productividad de los cultivos, mejorando la salud del suelo, y reduciendo el empleo de fertilizantes químicos.
Read MoreLos nemátodos parásitos de plantas son un grupo de gusanos microscópicos que viven en el suelo y atacan las raíces o partes aéreas de la mayoría de los cultivos, causando grandes pérdidas económicas.
Read MoreQueremos brindarte información sobre los diferentes tipos de Bioinoculantes, para que puedas elegir el que se adapta mejor a tu necesidad
Read More"El desconocimiento que tenemos sobre la biota del suelo, y en particular sobre la relación H:B, conlleva a que nosotros mismos ocasionemos desequilibrios microbiológicos en nuestros suelos".
Read More"Evaluación de indicadores biológicos como herramientas para conocer la biodiversidad del suelo y ayudar en la toma de decisiones sobre las prácticas de manejo para mantener la sustentabilidad del suelo".
Read MoreEs una herramienta de diagnóstico, que brinde información sobre indicadores bioquímicos y la diversidad biológica de un suelo, cuyos resultados, te ayudarán a diseñar un plan de manejo, optimizando el uso de los recursos.
Read More